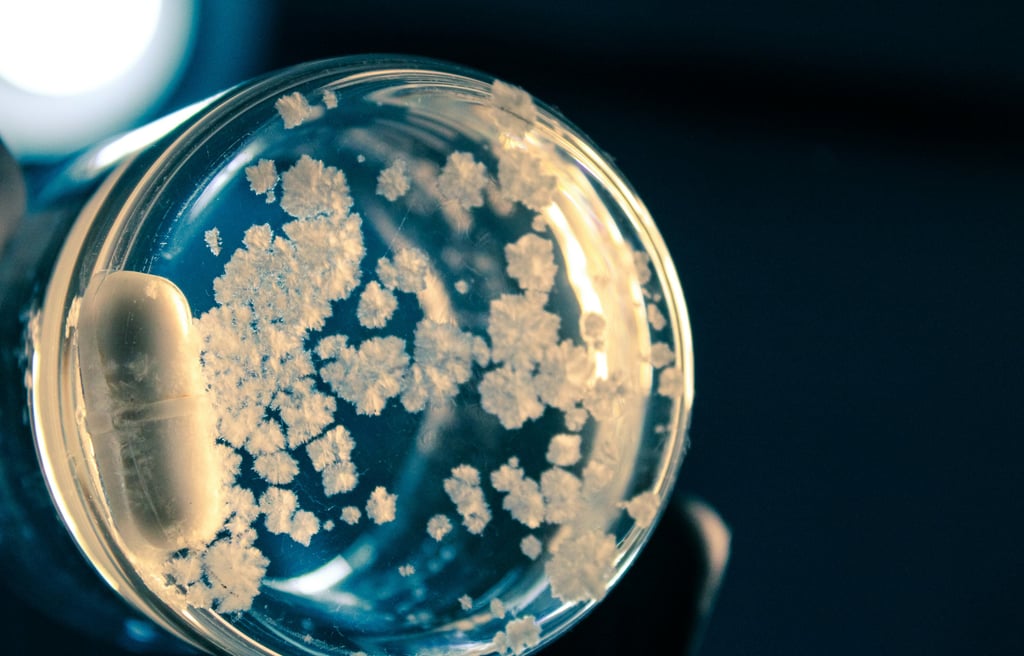
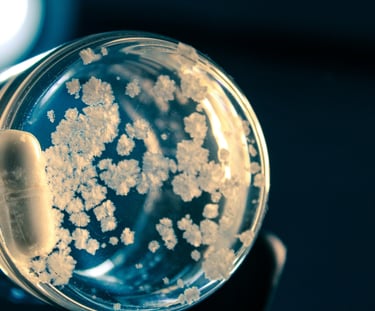

Secure, speedy, and reliable : Up to 70% Off!!!
Scientists unveil a powerful new way to engineer virus-based treatments to combat deadly drug-resistant infections
As antibiotic resistance continues to rise around the world, scientists are turning to an innovative and powerful solution: phage therapy. This cutting-edge approach uses naturally occurring viruses called bacteriophages to specifically target and destroy harmful bacteria — including strains that no longer respond to traditional antibiotics. Experts believe phage therapy could become a major weapon against the global threat of multidrug-resistant infections.
1/21/20263 min read

🦠 What Is Phage Therapy?
Phage therapy harnesses bacteriophages, or phages — viruses that infect and kill bacteria but leave human cells unharmed. Unlike broad-spectrum antibiotics, phages are highly specific, attacking only certain bacterial strains while preserving beneficial microbiota. This precision makes them a promising alternative or complement to antibiotics in fighting drug-resistant infections. (learning-gate.com)
Research shows that phages can replicate at infection sites and actively reduce bacterial populations, making them ideal candidates for treating stubborn and life-threatening infections. (fmhr.net)
🔬 Scientific Breakthroughs in Phage Research
Recent advances are accelerating the development of phage-based treatments:
Synthetic phage engineering: Scientists are developing custom phages designed to attack drug-resistant bacteria more effectively, unlocking the potential for tailored therapies. (Drug Target Review)
Precision phage cocktails: New combinations of phages — such as the Entelli-02 cocktail — have demonstrated powerful action against hospital-associated superbugs like multidrug-resistant Enterobacter species. (Open Access Government)
Deep mapping of phage structures: Structural insights into phage biology may enable more precise targeting and design of future therapeutics. (Technology Networks)
Combination therapies: Research suggests that pairing phages with antibiotics can enhance treatment effectiveness and reduce resistance development. (PubMed)
These breakthroughs highlight a rapidly evolving field poised to transform how bacterial infections are treated. (Frontiers)
💉 Why Phage Therapy Matters Now
Antibiotic resistance has become one of the most pressing global health challenges. According to public health agencies, common pathogens such as E. coli, Staphylococcus aureus, and Klebsiella pneumoniae have evolved resistance to many frontline antibiotics, making once-treatable infections potentially lethal. (fmhr.net)
In this context, phage therapy offers several promising advantages:
High specificity: Phages can target antibiotic-resistant bacteria without harming beneficial microbes. (learning-gate.com)
Self-amplification: Once a phage reaches its bacterial target, it can replicate and sustain its effect locally. (fmhr.net)
Lower toxicity: Early studies suggest phages are well tolerated with minimal side effects. (learning-gate.com)
Reduced resistance pressure: Because phages work differently from antibiotics, they provide a new route to suppress bacteria that have already developed resistance. (fmhr.net)
🌍 Real-World and Clinical Progress
While phage therapy is not yet widely approved in many countries, the research momentum is strong:
Preclinical success: Mouse studies have shown that bacteriophages can significantly reduce infections from antibiotic-resistant Klebsiella pneumoniae, a major healthcare-associated pathogen. (National Institutes of Health (NIH))
Ongoing clinical trials: Over 20 clinical trials around the world are exploring phage therapies for drug-resistant infections, fueling optimism for human applications. (excli.de)
Customized treatment tools: Researchers are developing AI-guided phage selection platforms to tailor cocktails for individual patients — a major step toward personalized antimicrobial therapy. (Technology Networks)
These developments suggest that phage therapy could soon transition from the laboratory to mainstream clinical use. (excli.de)
🧠 Challenges and Next Steps
Despite encouraging progress, challenges remain:
Bacterial defenses: Some bacteria can evolve resistance to phages, necessitating smarter cocktail designs and monitoring strategies. (Respiratory Therapy)
Regulatory hurdles: Phage therapy requires new frameworks for approval and manufacturing — a hurdle that policymakers and scientists are actively addressing. (World Economic Forum)
Standardized clinical evidence: Larger randomized clinical trials are needed to firmly establish safety and effectiveness across diverse infections. (excli.de)
Tackling these obstacles will be key to bringing phage therapy into everyday use. (excli.de)
🔍 Conclusion
As antibiotic resistance threatens to outpace the development of new drugs, phage therapy is reemerging as a powerful alternative or complement to antibiotics. Through engineered phage cocktails, precision targeting, and AI-driven personalization, scientists are rewriting the playbook for treating resistant bacterial infections. While challenges remain, the rapid pace of discovery and growing clinical trials signal a transformative era in infectious disease treatment — one where viruses may become the champions against superbugs. (Drug Target Review)
Sources
Scientists develop synthetic bacteriophages to fight drug-resistant bacteria — Drug Target Review (news) (Drug Target Review)
Phage therapy review: mechanisms, clinical promise, and challenges — Frontier in Medical & Health Research (fmhr.net)
NIH mouse study shows phage therapy could fight drug-resistant Klebsiella pneumoniae — NIH/ScienceDaily (National Institutes of Health (NIH))
Phage-antibiotic synergy research against MDR infections — PubMed summary (PubMed)
AI-guided phage therapy cocktail development — Technology Networks (Technology Networks)
Ongoing clinical trials and phage therapy pipeline growth — ClinicalPhage data (excli.de)
Contact
Questions? Reach out anytime, we're here to help.
© 2025. All rights reserved.
